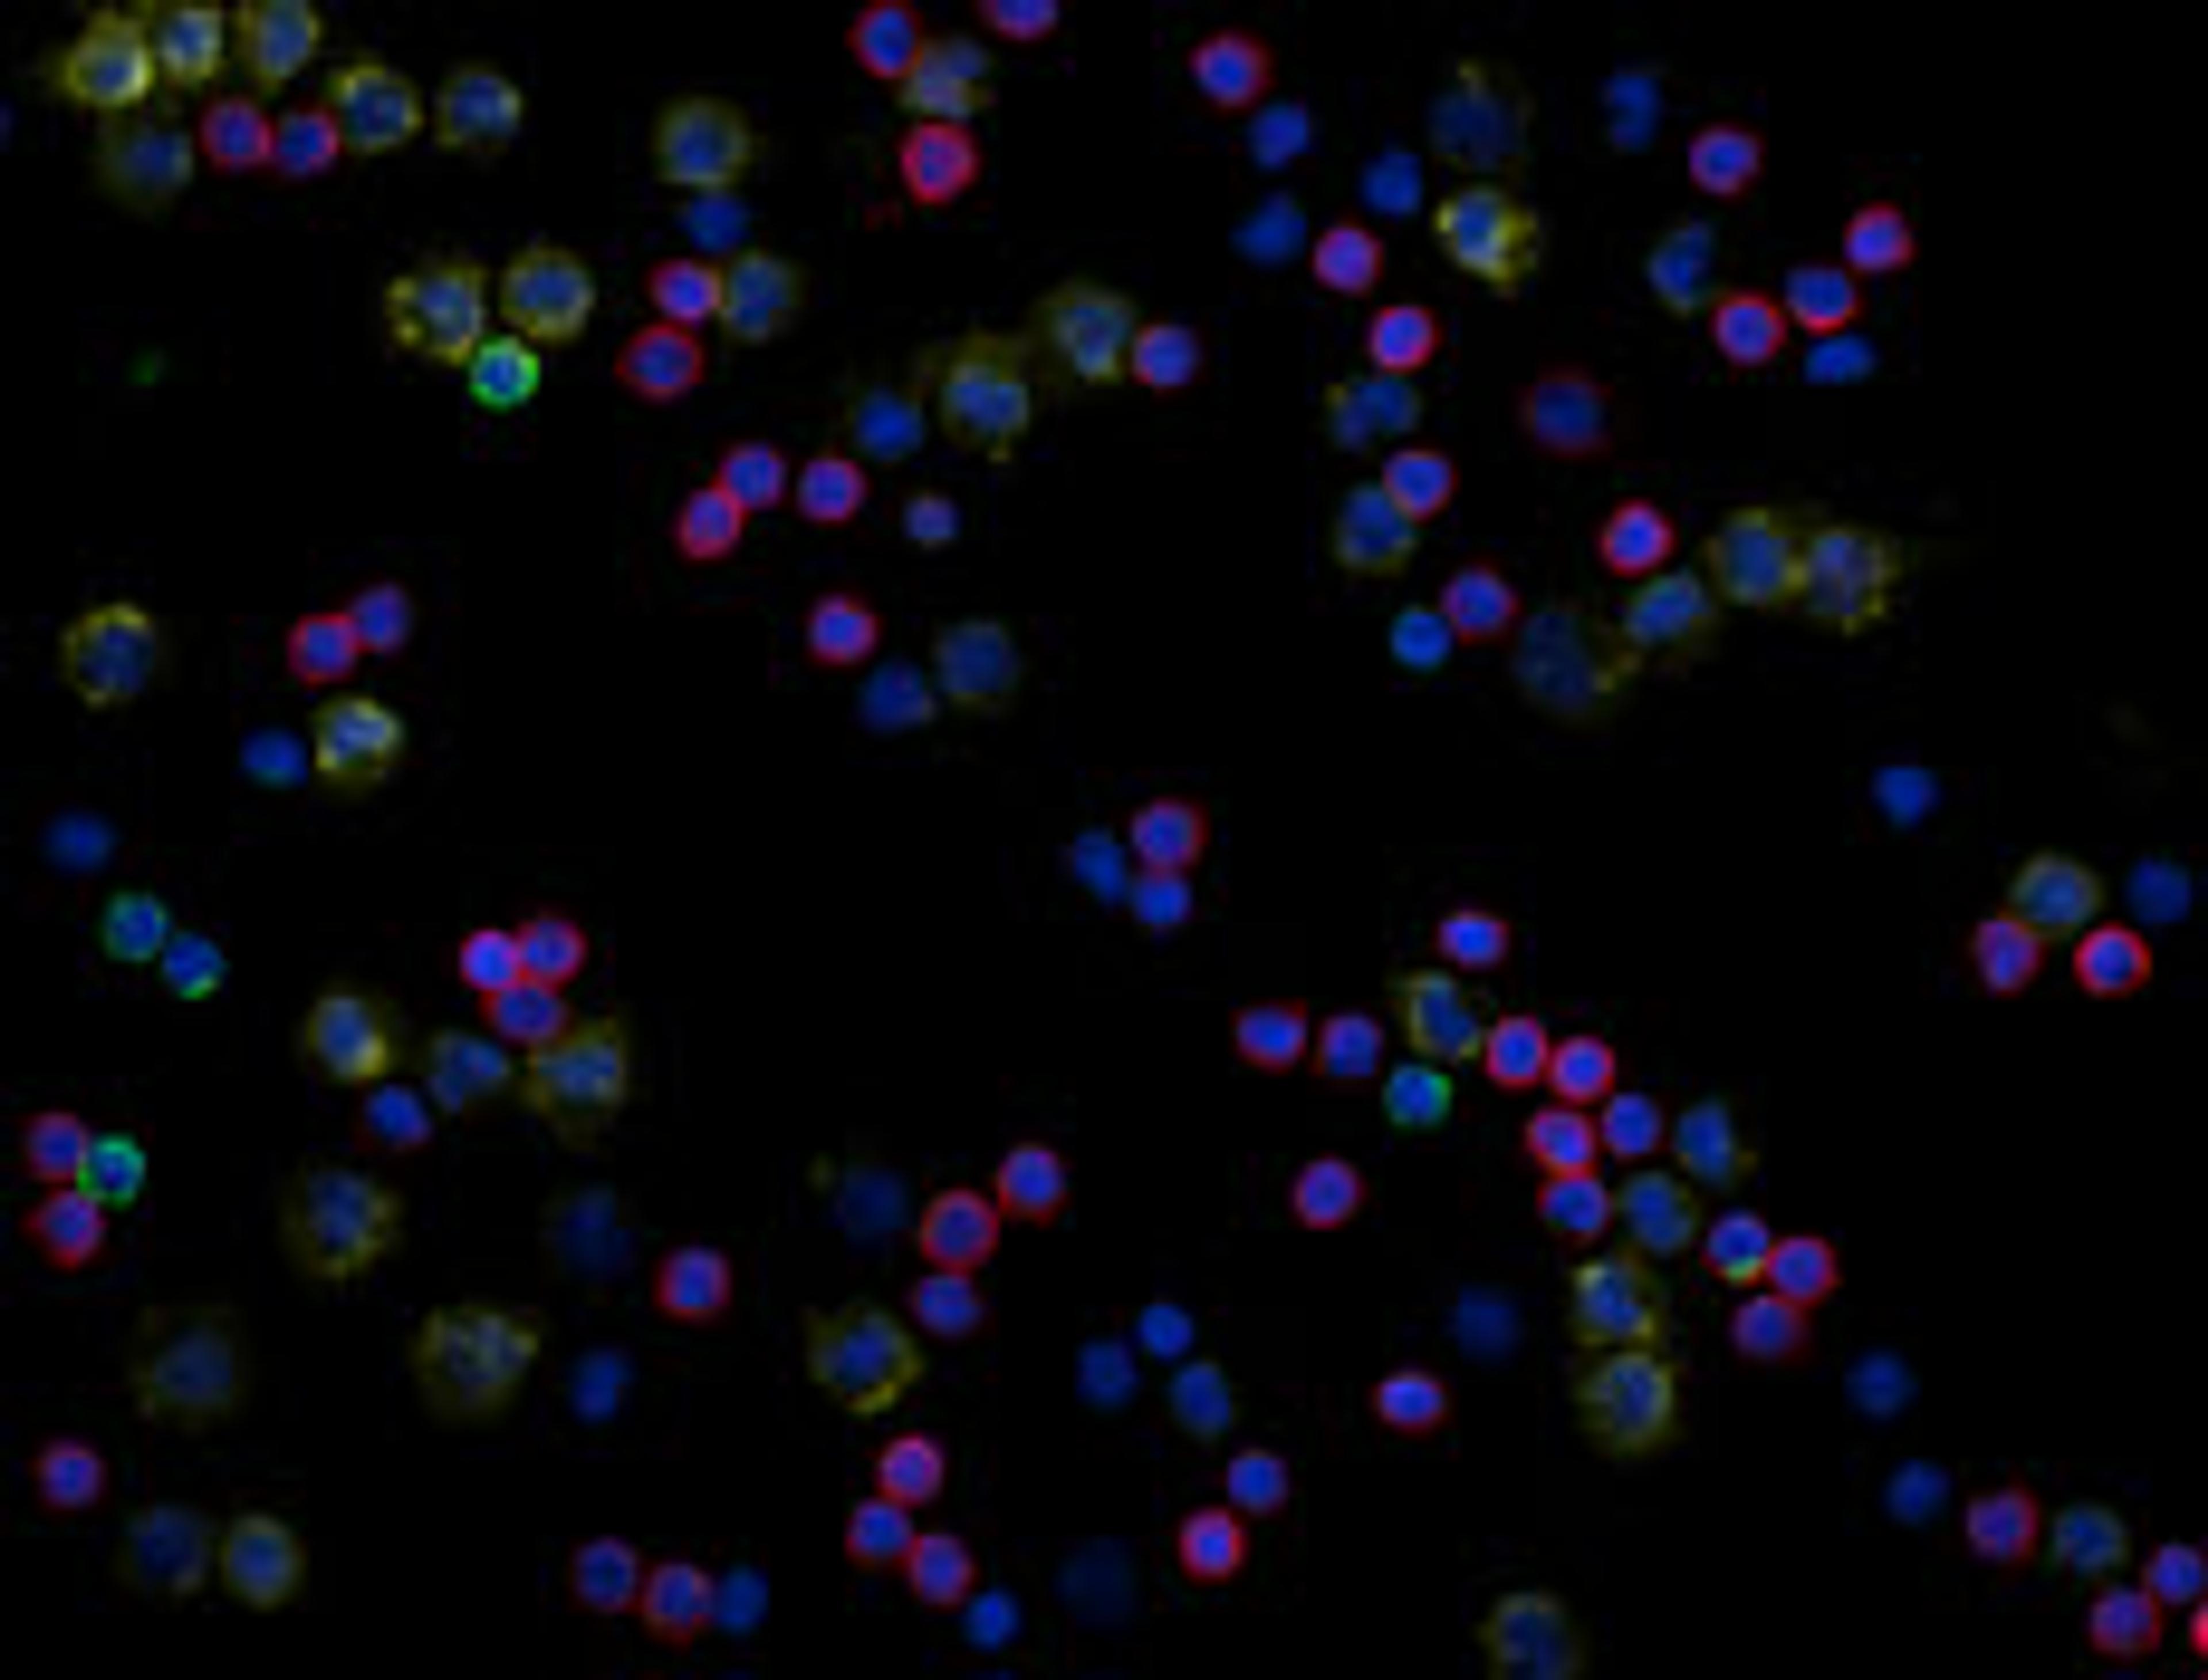
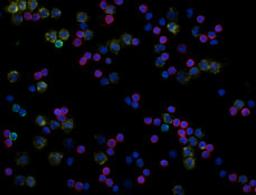

Product & ReviewsAntibodies
Alexa Fluor® 594 anti-human CD3
Alexa Fluor® 594 anti-human CD3; Clone: UCHT1; Reactivity: Human, Cross-Reactivity: Chimpanzee; Apps: IF, FC; Size: 100 μg
Product Details
- Cat. No.
- 300446
- Type
- Flow Cytometry Reagents
- Clonality
- Monoclonal
- Host
- Mouse

The supplier does not provide quotations for this antibody through SelectScience. You can search for similar antibodies in our Antibody Directory.
Reviews
Applications
- Flow Cytometry (FC)
- Immunofluorescence (IF)
Antibody Overview
About the company

BioLegend
BioLegend develops world-class, cutting-edge antibodies and reagents for biomedical research, manufactured at its state-of-the-art facility in San Diego, CA. BioLegend’s mission is to accelerate research and discovery by providing the highest quality products at an outstanding value, along with superior customer service and technical support.